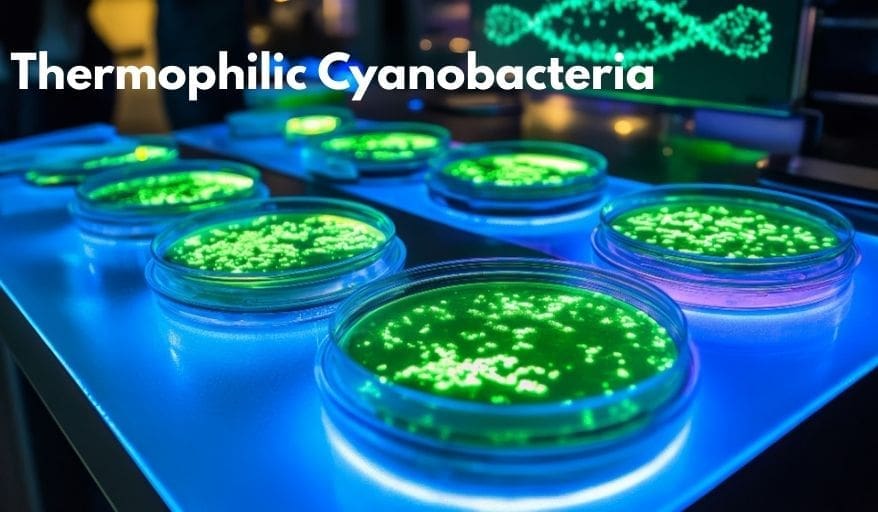
Thermophilic Cyanobacteria

Conserved Polyphosphate-Based Microcompartments in Thermophilic Cyanobacteria
Thermophilic cyanobacteria live in extreme heat. These tough microbes thrive in hot springs. They handle temperatures that would cook most living things. Scientists recently looked closer at their inner workings. They found special structures called stabilisomes. These tiny units act like survival packs for the cell. This discovery helps us understand how life survives in extreme environments. It also opens doors for new biotechnology careers.
The Power of Polyphosphate
Polyphosphate is a long chain of phosphate molecules. It stores energy for the cell. Thermophilic Cyanobacteria use it to stay alive during stress. The researchers isolated these polyphosphate-rich structures. They used a high-purity method to see them clearly. At the present time, we call these units stabilisomes.
Thermophilic Cyanobacteria feature a very specific chemical architecture. They contain minerals like calcium and magnesium. This mix helps stabilize the cell’s internal parts. To illustrate, think of them as tiny anchors. They hold everything together when the heat rises—even in scorching hot springs. As a result, these bacteria do not melt or fall apart. You can learn more about biological engineering careers to study such wonders.
How Scientists Isolated the Units
The team used Thermophilic Cyanobacteria for their study. These Thermophilic Cyanobacteria love the heat. At first, they broke the Thermophilic Cyanobacteria cells apart carefully. They did not want to damage the stabilisomes. After that, they used a centrifuge to separate the parts. This tool spins samples at very high speeds. To explain, it works like a salad spinner for Thermophilic Cyanobacteria cells.
The high-purity isolation was a big success. It showed that the architecture is conserved. This means different heat-loving bacteria use the same design. Another key point is the role of metal ions. These ions bond with the polyphosphate chains. This creates a solid, protective matrix. With this in mind, the cell stays strong.
Why This Matters for Your Future
This research is not just about old bacteria. It matters for STEM students today. Understanding protein stability is a huge goal. This knowledge helps us make better medicines. It also helps in creating biofuels. To put it another way, nature already solved these engineering problems. We are just learning the tricks.
There are many careers in science for curious minds. You could become a biochemist or a genetic engineer. These professionals design new ways to use microbes. All in all, the field of microbiology is growing fast. You can work in labs or outdoors in nature.
A Conserved Design for Survival
The study proves that nature is efficient. It uses the same chemical architecture across species. While this may be true, every species adds a tiny twist. The stabilisomes protect the cell’s DNA and proteins. Summing up, they are essential for life in hot springs.
Scientists used electron microscopy to see these tiny dots. The images showed dense, round structures. These are the polyphosphate stores. Prior to this study, we knew they existed. However, we did not know their full chemical makeup. Now, we have a clear map of their design.
Exploring STEM Opportunities
Do you like solving puzzles? This kind of research is like a giant puzzle. You look at tiny pieces to see the big picture. To list, you need skills in math, chemistry, and biology. At the same time, you need a creative mind.
Working with cyanobacteria is very exciting. These organisms changed our planet long ago. They produced the oxygen we breathe today. By comparison, they are the world’s oldest engineers. Studying them helps us plan for a hot future. To that end, your career in STEM starts with curiosity.
Final Thoughts on Microscopic Anchors
The stabilisomes are a marvel of evolution. They show how life adapts to any challenge. All things considered, these bacteria are masters of survival. With this intention, researchers will keep studying their molecular secrets.
Additionally, to stay updated with the latest developments in STEM research, visit ENTECH Online. Basically, this is our digital magazine for science, technology, engineering, and mathematics. Also, at ENTECH Online, you’ll find a wealth of information.
Reference
- Wang, C., Zhou, C., Song, X., Yin, J., Wang, M., & Yang, L. (2026). High-Purity isolation of Polyphosphate-Rich stabilisomes defines their conserved chemical architecture in thermophilic cyanobacteria. Plants, 15(3), 499. https://doi.org/10.3390/plants15030499